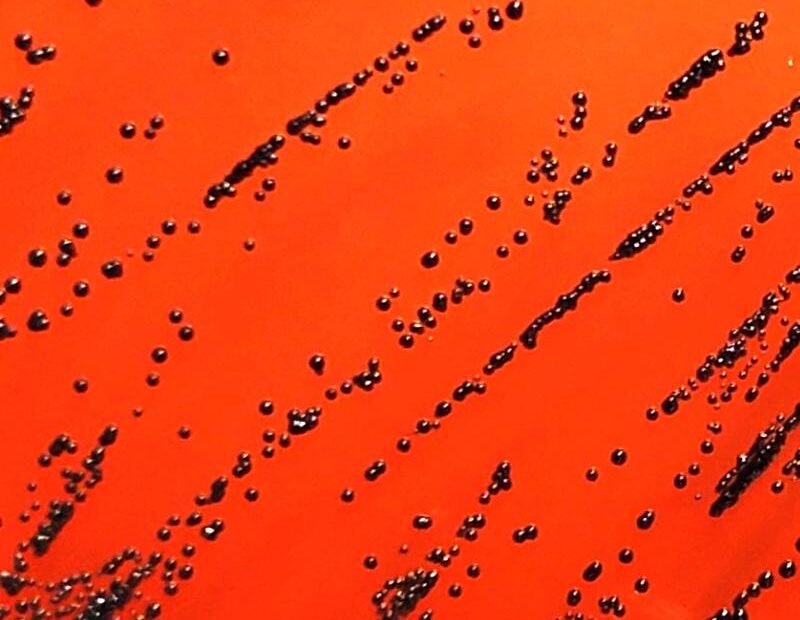
Typisch schwarze Kolonien von Diphtheriebakterien (Corynebacterium diphtheriae), kultiviert am Institut für Medizinische Mikrobiologie auf einem speziellen Nährmedium in einer Petrischale. | Quelle: Farah Fiechter und Frank Imkamp | Copyright: Universität Zürich

Bildschirme in Schulen keine Bedrohung
Bildschirme in Schulen sind kein Lernhindernis, sondern können gezielt eingesetzt das Lernen fördern, betonen Forscher der Universität Agder im neuen Sammelband „Logg på!“. Das Werk mit Beiträgen von 77 Experten fordert eine nuancierte Diskussion über digitale Technologien im Bildungswesen, weg von der pauschalen Darstellung als Bedrohung. Eine Pilotstudie von Lenka Garshol und Susan Erdmann zeigt, dass Bildschirme im Englischunterricht oft administrative Aufgaben rationalisieren, ähnlich wie traditionelle Papierübungen. Ungeeignete Nutzung ähnelte jedoch veralteten Lehrmethoden, nicht exzessivem Scrollen. Lehrer betonten den Nutzen digitaler Werkzeuge, insbesondere für Schüler mit Lese- und Schreibschwierigkeiten. Kjerstin Breistein Danielsen vom Teaching Lab der Universität plädiert für einen Fokus auf gutes Lernen statt polarisierender Pro- oder Contra-Debatten, um die digitale Kompetenz der Schüler zu stärken. Line Reichelt Føreland hebt das Potenzial von Videospielen wie Minecraft hervor, die im Unterricht über samische Kultur Inklusion fördern und zurückgezogenen Schülern eine…